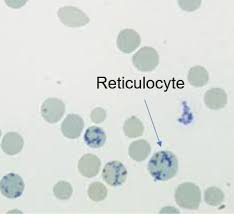

وتحتوي أيضًا على عضيات؛ مثل ميتوكوندريا، وريبوسوم، ولا تحتوي على نواة.
*الخلايا الشبكية: عبارة عن (shifting cells) يعني تنتقل من نخاع العظم إلى الدم؛ حيث تبقى في نخاع العظم يومين، ثم تنتقل إلى الدم؛ بحيث تحتاج إلى يوم واحد ثم تتحول إلى خلايا دم حمراء.
أهمية معرفة عدد الخلايا الشبكية
*عددها بالدم يدل على نشاط نخاع العظم (erythropoietic activity)، كل ما كان عددها أكثر، يدل ذلك على أن نخاع العظم يعمل بشكل كبير، والعكس صحيح.
*عددها بالدم يدل على نشاط نخاع العظم (erythropoietic activity)، كل ما كان عددها أكثر، يدل ذلك على أن نخاع العظم يعمل بشكل كبير، والعكس صحيح.
*وايضًا عددها مهم في تشخيص أمراض فقر الدم مثل: فقر الدم الانحلالي(Hemolytic anemia)، وفقر الدم اللاتنسجي (aplastic anemia).
*الان لعمل نسبة الصبغة للعينة ننظر إلى قيمة الهيموجلوبين Hb:
* إذا كان Hb =9 أو أعلى:
نأخذ نسبة متساوية من الصبغة وعينة الدم..
100 ميكرولتر من عينة الدم، و 100 ميكرولتر من الصبغة.
* إذا كان Hb =9 أو أعلى:
نأخذ نسبة متساوية من الصبغة وعينة الدم..
100 ميكرولتر من عينة الدم، و 100 ميكرولتر من الصبغة.
*أما إذا كان Hb من 7 إلى 9:
نأخذ 200 ميكرولتر من عينة الدم، و 100 ميكرولتر من الصبغة.
*وإذا كان Hb =7 أو أقل:
نأخذ 300 ميكرولتر من عينة الدم، و 100 ميكرولتر من الصبغة.
نأخذ 200 ميكرولتر من عينة الدم، و 100 ميكرولتر من الصبغة.
*وإذا كان Hb =7 أو أقل:
نأخذ 300 ميكرولتر من عينة الدم، و 100 ميكرولتر من الصبغة.
. بعد ما حددنا النسبة نحضر test tube، ونفرض أن Hb =10، نضيف إلى test tube …
100 ميكرولتر من عينة الدم، و 100 ميكرولتر من الصبغة، ونعمل mix.
*ثم نضع test tube في incubator لمدة 15 دقيقة على درجة حرارة 37.
*or incubate the test tube for 10 minute at 37 c (in water bath)
100 ميكرولتر من عينة الدم، و 100 ميكرولتر من الصبغة، ونعمل mix.
*ثم نضع test tube في incubator لمدة 15 دقيقة على درجة حرارة 37.
*or incubate the test tube for 10 minute at 37 c (in water bath)
2. ثم نعمل مسحة من الدم (smear of blood sample) على شريحة.
3. نتركها حتى تجف.
4. نضعها على عدسة oil immersion، دون cover slip.
3. نتركها حتى تجف.
4. نضعها على عدسة oil immersion، دون cover slip.
طريقة تحديد نسبة الخلايا الشبكية
أولا: نعد خلايا الدم الحمراء في أول field
*ما هو field: هو المساحة التي تراها عند النظر في المجهر.
*غالبا ما يتراوح عدد خلايا الدم الحمراء في field الواحد من 160 إلى 250 خلية.
أولا: نعد خلايا الدم الحمراء في أول field
*ما هو field: هو المساحة التي تراها عند النظر في المجهر.
*غالبا ما يتراوح عدد خلايا الدم الحمراء في field الواحد من 160 إلى 250 خلية.
* مثلا عدد الخلايا في field الاول = 250
250 × 4 = 1000
يعني راح نعد في 4 field.
ثانيا: نعد الخلايا الشبكية الموجودة في 4 field.
250 × 4 = 1000
يعني راح نعد في 4 field.
ثانيا: نعد الخلايا الشبكية الموجودة في 4 field.
ثالثا: نأتي للمعادلة:
reticulocytes(%)=(retics count / 1000 red cell) × 100
مثلا عدد الخلايا الشبكية = 10
التطبيق على المعادلة:
reticulocytes(%)= (10/1000) × 100
reticulocytes(%)= 1 %
reticulocytes(%)=(retics count / 1000 red cell) × 100
مثلا عدد الخلايا الشبكية = 10
التطبيق على المعادلة:
reticulocytes(%)= (10/1000) × 100
reticulocytes(%)= 1 %
*** لما يكون في فقر دم، والهيماتوكريت أقل من 35%، ونسبة الخلايا الشبكية أعلى من 2.5 %، بعمل correction retics، بستخدمه لانه عدد خلايا الدم الحمراء قليل بالتالي سوف أعد field أكثر، لذلك يحتاج إلى هذا التصحيح.
** المعادلة
correction retics= retics count % × ( patient hematocrit / normal hematocrit (45%) )
مثلا:
retics count % =10%
patient hematocrit = 22%
normal hematocrit = ثابت % 45
التطبيق:
correction retics= 10 % × (22/45)
correction retics= 4.9%
correction retics= retics count % × ( patient hematocrit / normal hematocrit (45%) )
مثلا:
retics count % =10%
patient hematocrit = 22%
normal hematocrit = ثابت % 45
التطبيق:
correction retics= 10 % × (22/45)
correction retics= 4.9%
** ولانو في فقر دم، وعدد خلايا الدم الحمراء جدا قليل، نخاع العظم سوف ينتج خلايا ويطلعها للدم قبل ما تنضج(shift reticulocytosis)، لذلك الخلايا الشبكية لن تبقى بالنخاع لمدة يومين، وسوف تذهب إلى الدم، وهي غير ناضجة بشكل كافي،
وبالتالي سوف يظهر بالدم خلايا شبكية ناضجة بشكل كافي ومستعدة للتحول إلى خلايا حمراء، وخلايا شبكية أقل نضوج، وتحتاج إلى وقت أطول للتحول إلى خلايا دم حمراء..لمعالجة هذا سوف نحتاج إلى ما يعرف Reticulocyte production index اختصارًا RPI.
النسبة الطبيعية للخلايا الشبكية:
البالغين: 0.5 -2 %
حديث الولادة: 2.5 -6 %
البالغين: 0.5 -2 %
حديث الولادة: 2.5 -6 %
مثال شامل كل القوانين:
الهيماتوكريت: 15%
Hb: 7
retics count: 9
** للوهلة الاولى من عدد الخلايا الشبكية واضح أن نخاع العظم استجاب لفقر الدم..لكن
correction retics= 9% × (15/45)
correction retics = 3%
الهيماتوكريت: 15%
Hb: 7
retics count: 9
** للوهلة الاولى من عدد الخلايا الشبكية واضح أن نخاع العظم استجاب لفقر الدم..لكن
correction retics= 9% × (15/45)
correction retics = 3%
RPI = 3% / 2.5
RPI = 1.2%
** ولكن لما عملنا تصحيح توضح لدينا أن الاستجابة قليلة من نخاع العظم.
RPI = 1.2%
** ولكن لما عملنا تصحيح توضح لدينا أن الاستجابة قليلة من نخاع العظم.
** anemia with reticulocytosis = hemolytic anemia
يعني فقر دم مع نسبة خلايا شبكية أعلى من الطبيعي يحدث بسبب hemolytic anemia، يعني نخاع العظم شغال.
يعني فقر دم مع نسبة خلايا شبكية أعلى من الطبيعي يحدث بسبب hemolytic anemia، يعني نخاع العظم شغال.
** anemia with reticulocytopenia = aplastic anemia
يعني فقر دم مع نسبة خلايا شبكية قليلة يحدث بسبب aplastic anemia، يعني نخاع العظم مش شغال.
يعني فقر دم مع نسبة خلايا شبكية قليلة يحدث بسبب aplastic anemia، يعني نخاع العظم مش شغال.
Loading suggestions...